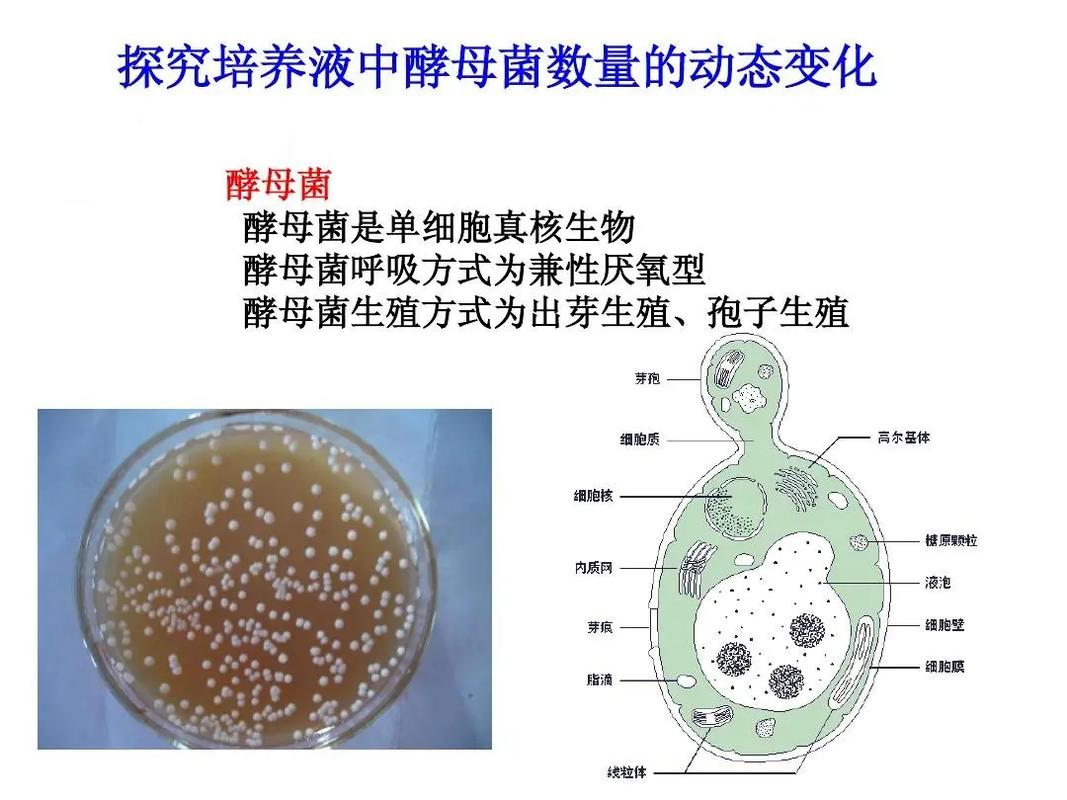
发酵原理（酵母菌做馒头发酵原理）

本文目录一览:
泡菜发酵的原理是什么?
原理:泡菜制作过程的发酵主要是乳酸菌进行的无氧发酵。利用酵母、乳酸菌等多种微生物对泡菜中的碳水化合物进行生物降解,在多种酶的生物催化作用下,泡菜中的长链分子糖类在乳酸菌等微生物细胞内氧化为3-5个碳原子的短链有机酸,使泡菜呈酸性,以抑制和杀灭其他有害的腐败微生物的过程,就是泡菜的发酵过程。

泡菜发酵原理 泡菜发酵主要依靠乳酸菌的作用。乳酸菌在无氧环境下分解蔬菜中的糖分,产生乳酸等有机酸,从而使泡菜具有独特的酸味和口感。这一过程中,泡菜水的酸度逐渐升高,形成不利于有害微生物生长的环境,从而保证了泡菜的安全和品质。
泡菜发酵的原理是乳酸菌等微生物在适宜条件下将蔬菜中的糖分等分解转化。温度对发酵有影响,常温下乳酸菌也能进行发酵,只是速度可能不同。放冰箱发酵的好处是能一定程度控制发酵速度,让泡菜发酵得更缓慢、稳定,可能使泡菜口感更细腻。

泡菜发酵的原理:泡菜的发酵主要是由乳酸菌进行的一种无氧发酵过程。在酵母、乳酸菌等多种微生物的作用下,泡菜中的碳水化合物被生物降解,长链分子糖类在乳酸菌等微生物的细胞内被氧化成3-5个碳原子的短链有机酸,使泡菜呈现出酸性,从而抑制和杀灭其他有害的腐败微生物。
自然发酵的乳酸菌泡菜的核心发酵菌种是蔬菜表面附着的天然乳酸杆菌(如肠膜明串珠菌、植物乳杆菌等)。在盐渍环境下,有害菌被抑制,乳酸菌成为优势菌群,将蔬菜中的糖类转化为乳酸,形成酸爽口感。例如德国泡菜和东北酸菜均依赖此原理,发酵时间越长酸味越明显(pH可降至5以下)。
简述发酵面团的发酵原理
1、发酵面团的发酵原理是在一定温度、湿度条件下,让酵母充分繁殖产气,促使面团膨胀的过程。具体来说:酵母作用:酵母菌在面团内部有氧的环境下,会将淀粉转化为糖并消耗掉,这个过程中会释放出二氧化碳气体和乙醇。面团膨胀:释放出的二氧化碳气体被面筋网络所包裹,形成均匀细小的气孔,从而使面团膨胀起来。
2、发酵面团的发酵原理简述如下:发酵面团的过程是在一定温度、湿度条件下,利用酵母的繁殖和产气作用,促使面团膨胀的过程。这一过程涉及多个生物化学反应,具体如下:酵母的作用:繁殖产气:酵母在面团中繁殖时,会消耗面团中的氧气和糖分,产生二氧化碳气体和乙醇。这是面团发酵的主要动力来源。
3、面团发酵的原理是一个涉及微生物学、化学和物理变化的复杂过程,其核心在于酵母菌的代谢活动与面团结构的相互作用。
酵母菌的发酵原理是什么
酵母菌的发酵原理主要是利用酵母菌的代谢活动将面团中的葡萄糖转化为水和二氧化碳气体,从而使面团膨胀、松软。以下是关于酵母菌发酵原理的详细解释: 酵母菌的代谢活动:酵母菌作为发酵素,在面团中吸收养分并生长繁殖。在代谢过程中,酵母菌将面粉中的葡萄糖分解为水和二氧化碳气体。
酵母菌的发酵原理主要是其通过吸收面团中的养分进行生长繁殖,并将面粉中的葡萄糖转化为水和二氧化碳气体。以下是关于酵母菌发酵原理的详细解释: 葡萄糖的转化:酵母菌在面团中主要吸收葡萄糖作为能量来源。在代谢过程中,酵母菌将葡萄糖分解为水和二氧化碳气体。
酵母菌的发酵原理:酵母菌在无氧条件下,通过代谢葡萄糖产生乳酸或丙酮酸,随后在缺氧和微酸性的环境中,丙酮酸转化成酒精。这一过程的产物主要是酒精。酵母菌作为基因克隆实验中常用的真核生物受体细胞,其培养过程与大肠杆菌相似,具有便捷性。
酵母菌的发酵原理是:酵母菌作为发酵素,吸收面团中的养分并生长繁殖,将面粉中的葡萄糖转化为水和二氧化碳气体,使面团膨胀、松软,产生蜂窝状的组织结构。以下是关于酵母菌发酵原理的进一步解释及影响发酵的因素:发酵原理详解: 养分吸收与生长繁殖:酵母菌在面团中吸收养分,进行生长和繁殖。
酵母菌的发酵原理是吸收面团中的养分并生长繁殖,将面粉中的葡萄糖转化为水和二氧化碳气体,使面团膨胀、松软,产生蜂窝状的组织结构。具体解释如下:葡萄糖转化:酵母菌在发酵过程中,主要利用面团中的葡萄糖进行代谢,产生水和二氧化碳气体。这些气体在面团中形成气泡,使面团膨胀,形成松软的结构。
酵母菌发酵原理是酵母菌进行无氧呼吸产生乳酸,酵母菌分解葡萄糖产生丙酮酸,丙酮酸在缺氧和微酸性的条件下,转变成酒精,产物是酒精。酵母菌含有多种酶,例如淀粉酶。发酵时,淀粉酶先使面粉中的淀粉变成糖分,然后使糖生成二氧化碳。
本文来自作者[达雷]投稿,不代表米雪号立场,如若转载,请注明出处:https://vimx.cn/xiwen/202509-22020.html
评论列表(3条)
我是米雪号的签约作者“达雷”
本文概览:本文目录一览: 1、泡菜发酵的原理是什么? 2、简述发酵面团的发酵原理...
文章不错《发酵原理(酵母菌做馒头发酵原理)》内容很有帮助